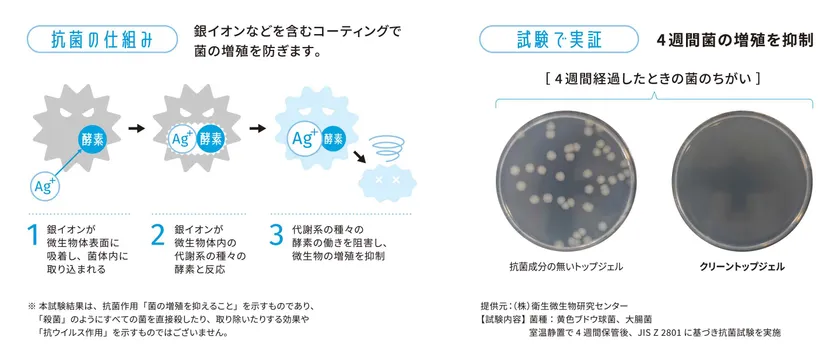

抗菌作用のあるジェルネイル「クリーントップジェル」 日本上陸20周年の「Calgel(カルジェル)」から7月25日新発売 =8月15日より取り扱いサロンの案内も開始=
株式会社 MOGA・BROOK(所在地:東京都渋谷区、代表取締役社長:戸田 学、以下「当社」)が2002年より取り扱うソフトジェルネイルブランド「Calgel(カルジェル)」は、ジェルネイルの仕上げに使用するトップジェルに抗菌作用をプラスした「クリーントップジェル」を7月25日(月)に新発売いたしました。また8月15日(月)より公式サイトにて取り扱いサロンの案内を開始いたしました。

「クリーントップジェル」を7月25日(月)に新発売
「クリーントップジェル」詳細案内: https://mogabrook.com/2022/06/10/calgel_clean_topgel
■「Calgel(カルジェル)」とは
「Calgel(カルジェル)」は海外では40年以上前から数々のネイルサロン、ヘアサロン、エステサロン、スパなどで愛されているUVライト・ハイブリッドライト・一部ジェルはLEDライトで硬化し爪への負担をかけない画期的なジェルネイルです。日本には2002年、MOGA・BROOK(モガ・ブルック)のプロデュースにより上陸、地爪に優しいネイルとして認知されています。ジェルオフ(ジェルリムーブ)も簡単で、オフによるダメージが少なく地爪に優しい施術システムです。地爪に近い柔軟性の設計でフィットし、爪が弱い方や傷んでしまった爪をサポート。高い定着力があるため、3~4週間美しい状態をキープします。カラーには化粧品に使用が認められている顔料のみを使用し、プロのネイリストが厳選した上品なカラーバリエーションを取り揃えています。
※MOGA・BROOK は「カルジェル」世界の統括本部および教育本部です。
4週間にわたり菌の増殖を抑制
■抗菌・清潔な爪先を保つジェルネイル
「クリーントップジェル」はジェルネイルの仕上げに使用するトップジェルに抗菌作用をプラスした新製品です。銀イオンなどを含むコーティング剤により、菌の増殖を抑制します。(※)第三者機関である衛生微生物研究センターの調査により、4週間にわたり菌の増殖を抑える働きが認められました。(図参照)いつものようにネイルのお洒落を楽しみながら、ジェルをオフするまで菌の増殖を防ぎ、常に清潔な爪先をキープすることができます。普段ネイルをされる習慣がない方、日々さまざまな物に触れる指先を清潔に保ちたい方、衛生管理が特に必要な職業に就かれている方にもおすすめです。ジェルネイルをしながら清潔な爪先を保ち、手指衛生の意識を高めることで、ネイル文化の新しい可能性と発展に寄与します。
※代表的2菌(黄色ブドウ球菌・大腸菌)による検査で、全ての菌において有効性が確認されたものではありません。
試験依頼先:(株)衛生微生物研究センター
■「身だしなみ」としてのネイルの提案
日本ではまだ「ネイル=華美なもの」のイメージが強く、職業や年齢・性別によって制約があったり敬遠されたりすることが多いという現状があります。海外ではネイルを整えることは女性・男性問わず身だしなみの一つであり、誰もが自由に楽しむものでもあります。今回の「クリーントップジェル」の新発売により、普段制約がある方のネイルに対するハードルを下げ、ネイルの制限が生じる職業やシーンでの制限緩和に寄与します。また衛生管理の役割を果たすネイルアイテムの登場により、ネイルに対するイメージ向上も期待しています。
■8月15日より取り扱いサロンの案内を開始
カルジェルを体験いただけるサロンは全国各地にございます。地爪への優しさにこだわったカルジェルで、爪をすこやかに保ちながらネイルをお楽しみいただけます。全国のカルジェルサロンは当社WEBサイトよりご確認ください。
またクリーントップジェルの発売に伴い、「クリーントップジェル取扱サロン」の一覧も公開いたします。メーカーの認定を受けたサロンで安心して施術を受けていただくことが可能です。是非お近くのサロンでクリーントップジェルをお試しください。
カルジェルサロン一覧: https://mogabrook.com/salon
取り扱サロン一覧 : https://mogabrook.com/cleantopsalon

カルジェル クリーントップジェル
■商品概要
商品名:カルジェル クリーントップジェル3.5g CGCTGS
価格 :4,620円(税込)
容量 :3.5g
サイズ:W30 H20 D31(mm)
■会社概要
会社名 : 株式会社 MOGA・BROOK
所在地 : 東京都渋谷区神宮前1-10-29
代表 : 代表取締役社長 戸田 学
設立 : 2002年(平成14年)4月15日
資本金 : 8,000万円
事業内容: 化粧品・美容器具の輸出入、卸売販売および製造開発ならびに
新商品の開発計画・企画・立案およびマーケティングリサーチ/
ネイルスクール及びカルジェル講習(本科、エクスプレス、
スタンダード、ファンデーション、ファンデーションSP他)の運営/
ネイルサロンおよび美容室の経営/
ネイル、メイクアップサロンに関する講演・講習会の開催・
運営およびコンサルティング業務/カルジェルビジネスの拡大/
前記各号に付随関連する一切の業務
URL : https://mogabrook.com/



















